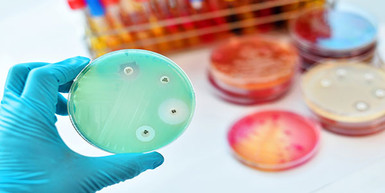
Everything You Need To Know About Antimicrobials Everything You Need To Know About Antimicrobials

Posted by jwb on May 19th 2023
Stained Concrete Floors – Benefits, Color & FAQs
Introduction:Stained concrete floors have become increasingly popular in homes due to their versatility, durability, and aesthetic appeal. This blog post explores the benefits of stained concrete floo
…